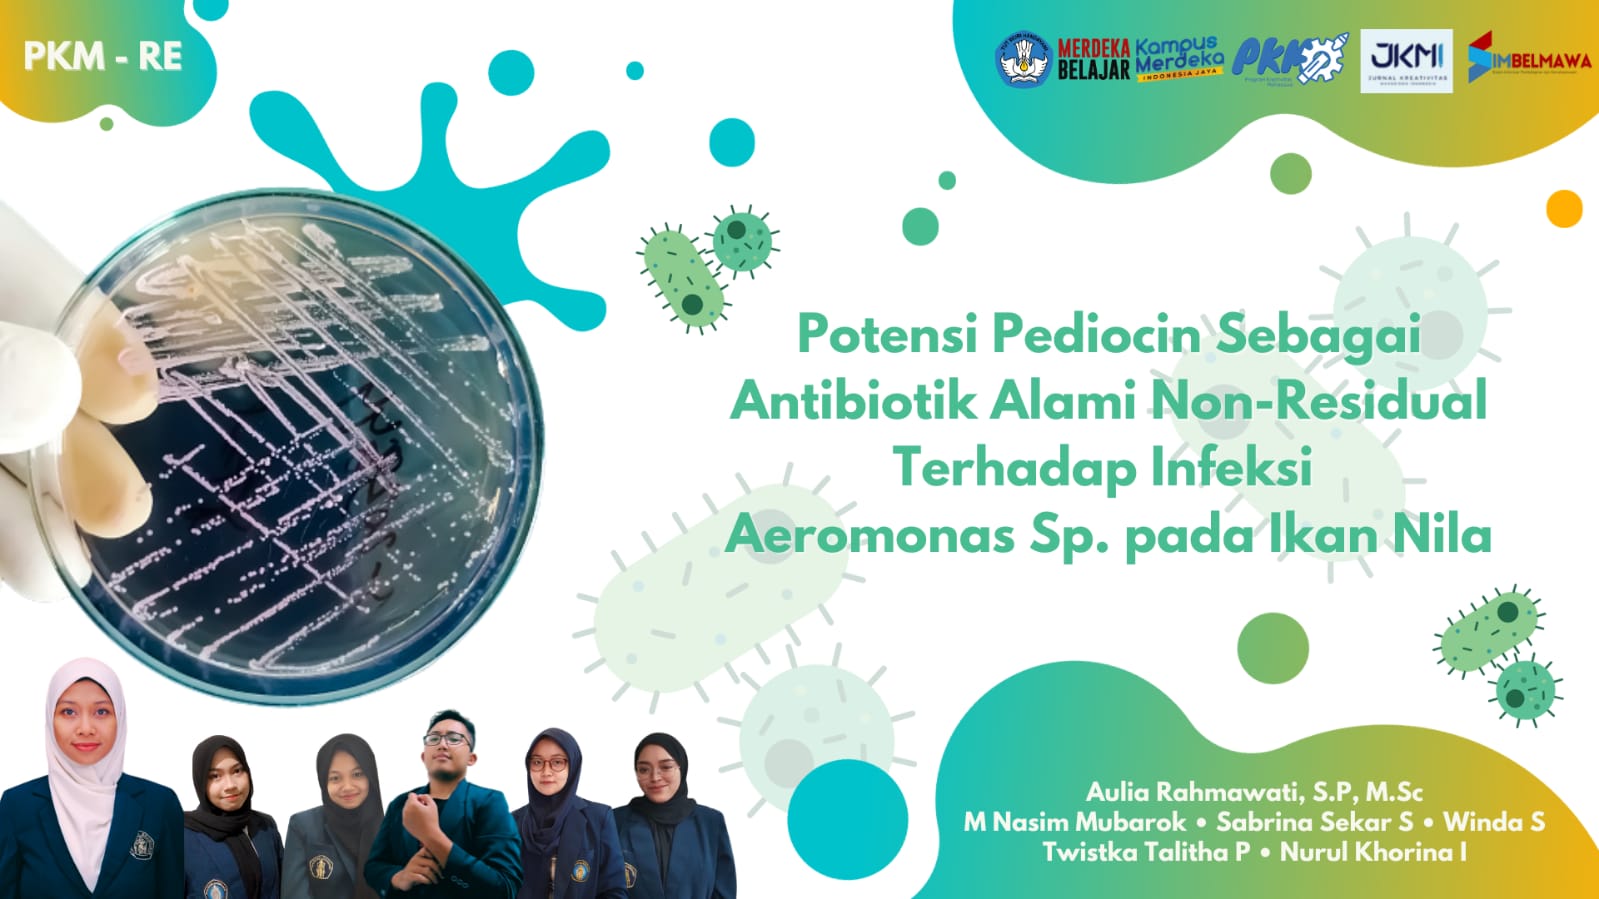

PORTALBANGSA.CO.ID – Lima Mahasiswa Universitas Brawijaya (UB) dibawah bimbingan ibu Aulia Rahmawati S.P.,M.Sc. meneliti potensi pediocin sebagai antibiotik alami tanpa residu untuk budidaya ikan nila. Penelitian ini bermula dari tingginya kasus kematian ikan nila akibat bakteri Aeromonas yang mencapai 80%.
Permasalahan ini turut menyebabkan turunnya hasil panen budidaya ikan nila di beberapa daerah penghasil komoditi ini. Penanganan infeksi oleh aeromonas yang selama ini dilakukan petani tambak adalah dengan pemberian antibiotik.
Namun, penggunaan antibiotik dalam budidaya ikan dapat memiliki konsekuensi yang tidak diinginkan, seperti residu antibiotik dalam ikan, resistensi antibiotik, dan efek samping pada lingkungan dan manusia.
Oleh karenanya, kelima mahasiswa yang diketuai oleh Muhammad Nasim Mubarok, yang beranggotakan Sabrina Sekar Syalsabillah, Twistka Talitha Pangestu, Nurul Khorina Ilmi, dan Winda Setyaningrum, hadir untuk menjawab permasalahan serius bagi para petani budidaya nila.
Sekumpulan mahasiswa dari gabungan program studi Budidaya Perairan, Biologi dan Ilmu Kelautan melihat potensi dari pediocin. Pediocin sebagai senyawa yang dihasilkan bakteri asam laktat dari genus Pediococcus, mempunyai aktivitas antimikroba.
Diantaranya seperti Staphylococcus aureus, Listeria monocytogenes, Bacillus cereus, dan Escherichia coli. Karena kemampuannya untuk membunuh bakteri patogen, pediocin telah dianggap sebagai agen antibiotik alami.
Meskipun memiliki sifat antimikroba yang serupa dengan antibiotik, pediocin berbeda dari antibiotik karena tidak meninggalkan residu dan menimbulkan resistensi bakteri (Mathur & Field, 2017).
Dalam beberapa riset, pediocin memiliki hasil yang positif saat diterapkan sebagai antibiotik di dunia peternakan seperti peternakan sapi, namun tidak pernah di dunia perikanan.
Dalam hasil penelitian yang telah dilakukan, pediocin memiliki efektivitas yang baik dalam menghadapi infeksi Aeromonas.
Hal ini telah dibuktikan dalam berbagai uji di dalamnya meliputi uji daya hambat, uji tantang, hingga uji hemtologi.
Hasil ini tentunya memberikan pandangan pandangan baru dalam dunia perikanan dalam menghadapi masalah infeksi bakteri Aeromonas yang dapat menyebabkan kematian massal pada komoditas.
Penulis : Muhammad Nasim